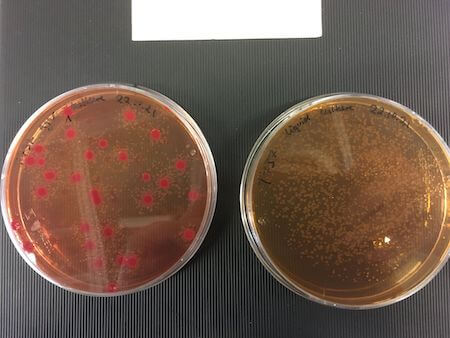
Klebsiella michiganensis (red) is only able to receive the P3 plasmid from S. Typhimurium (yellow) when they are grown together on agar plates (left), not in liquid culture (right).

Plasmids and the Spread of Antibiotic Resistance Genes

Source: Getting et al./Microbiology Spectrum, Jan. 2018
Although conjugation is well-understood on a molecular level, how it plays out in the environments that bacteria really inhabit, rather than the lab, is much less clear. One especially versatile gastrointestinal pathogen, Salmonella entericaserovar Typhimurium, is particularly interesting for studies on resistance gene sharing because it forms so-called persister reservoirs in its hosts. In these cases, antibiotic-resistant cells lurk in the gut tissue or other organs after an infection and migrate back into the gut lumen to cause reinfections after the antibiotic pressure is gone.
Helper Plasmids Facilitate Conjugation
As S. Typhimurium frequently encounters gut bacteria, plasmid sharing, and the spread of resistance genes, is a real concern. A study recently published in ASM’s Journal of Bacteriology discovered that a particular strain of S. Typhimurium, known as SL1344, shares its plasmids with other bacteria using the assistance of another plasmid. The study, led by researchers at ETH Zurich in Switzerland, focused on a plasmid that encodes resistance genes for streptomycin and sulfonamides, called P3 for short. However, P3 lacks the genes for the conjugation machinery itself, meaning it needs a 'helper’ plasmid to move between cells; in S. Typhimurium this helper plasmid is known as P2.
On a sequence level, P3 very closely resembles another plasmid known as pRSF1010, which has a broad host range, meaning it can replicate in a wide variety of bacterial species. Thus, the researchers hypothesized that P3 may be transferred from S. Typhimurium to diverse bacterial species in the mammalian gut environment, potentially spreading antibiotic resistance genes as it goes. The hypothesis was tested using mice.

Source: Marla Gaissmaier
The mice were first infected with one of the recipient bacterial species, including representatives of the human gut flora, then with S. Typhimurium 24 hours later. The researchers then monitored the growth of both the recipient and S.Typhimurium, as well as the frequency of P3 transfer, by analyzing the feces of the mice over 3 days. They identified P3 transfer, mediated by P2, occurring between S. Typhimurium and 4 recipients belonging to the class Gammaproteobacteria, representing gut commensals as well as plant-associated bacteria.
Altogether, P3 appears to be very “shareable” among diverse bacteria, within and beyond the mammalian gut. However, the researchers did not expect the plasmid to be transferred if there was no antibiotic pressure, as it would not directly benefit the bacteria to harbor resistance genes. They were surprised by their findings. “For me, the most striking thing was that…the plasmid was taken up by other bacteria even without the selective pressure [of antibiotics],” explains Marla Gaissmaier, first author of the study and now a doctoral student at LMU Munich in Germany. “I didn’t even challenge the bacteria with streptomycin, so there was no directly visible fitness advantage in taking up the plasmid."
The Plasmid Paradox
However, it remains unclear whether P3 persists in its recipients long-term and why it was transferred in the first place, even when it did not directly benefit the bacteria. This is known as the ‘plasmid paradox,’ to which several solutions have been proposed. For example, the plasmid may carry unknown fitness benefits besides antibiotic resistance. Indeed, a recent study using another broad host range resistance plasmid showed that it can have a wide range of effects across different recipient strains, with some gaining a fitness benefit by maintaining the plasmid. Alternatively, the plasmid may also be acting as purely ‘selfish DNA,’ only concerned with their own persistence and replication.
Source: Marla Gaissmaier
Managing the AMR Crisis
Best practice guides urge the reduced use and abuse of antibiotics in both clinical and agricultural settings in order to reduce the selective pressure for transfer of resistance genes. Therefore, the spread of plasmids such as P3 and RP4 in the absence of this pressure is concerning, as it suggests that reducing antibiotic use and pollution may not be enough to curb rising resistance. “This means that antibiotic resistance can spread even when antibiotics are not involved,” Gaissmaier explained—a “scary thought."Altogether, studies that probe the mechanisms and dynamics of plasmid transfer among bacteria are vitally important. By understanding where, how and how often plasmids are shared, we can continue to seek and develop solutions for emerging multidrug-resistant pathogens, as well as quantify risks and manage the world’s ever-growing populations of antibiotic resistant pathogens. What’s more, we can also understand what makes a plasmid ‘shareable,’ and even how to stop conjugation from happening to curb the spread of antibiotic resistance. Sun Tzu’s famous phrase—“know thy enemy”—takes on new meaning in the face of the antimicrobial resistance crisis.
Learn more about Antimicrobial Resistance on our resource page.
